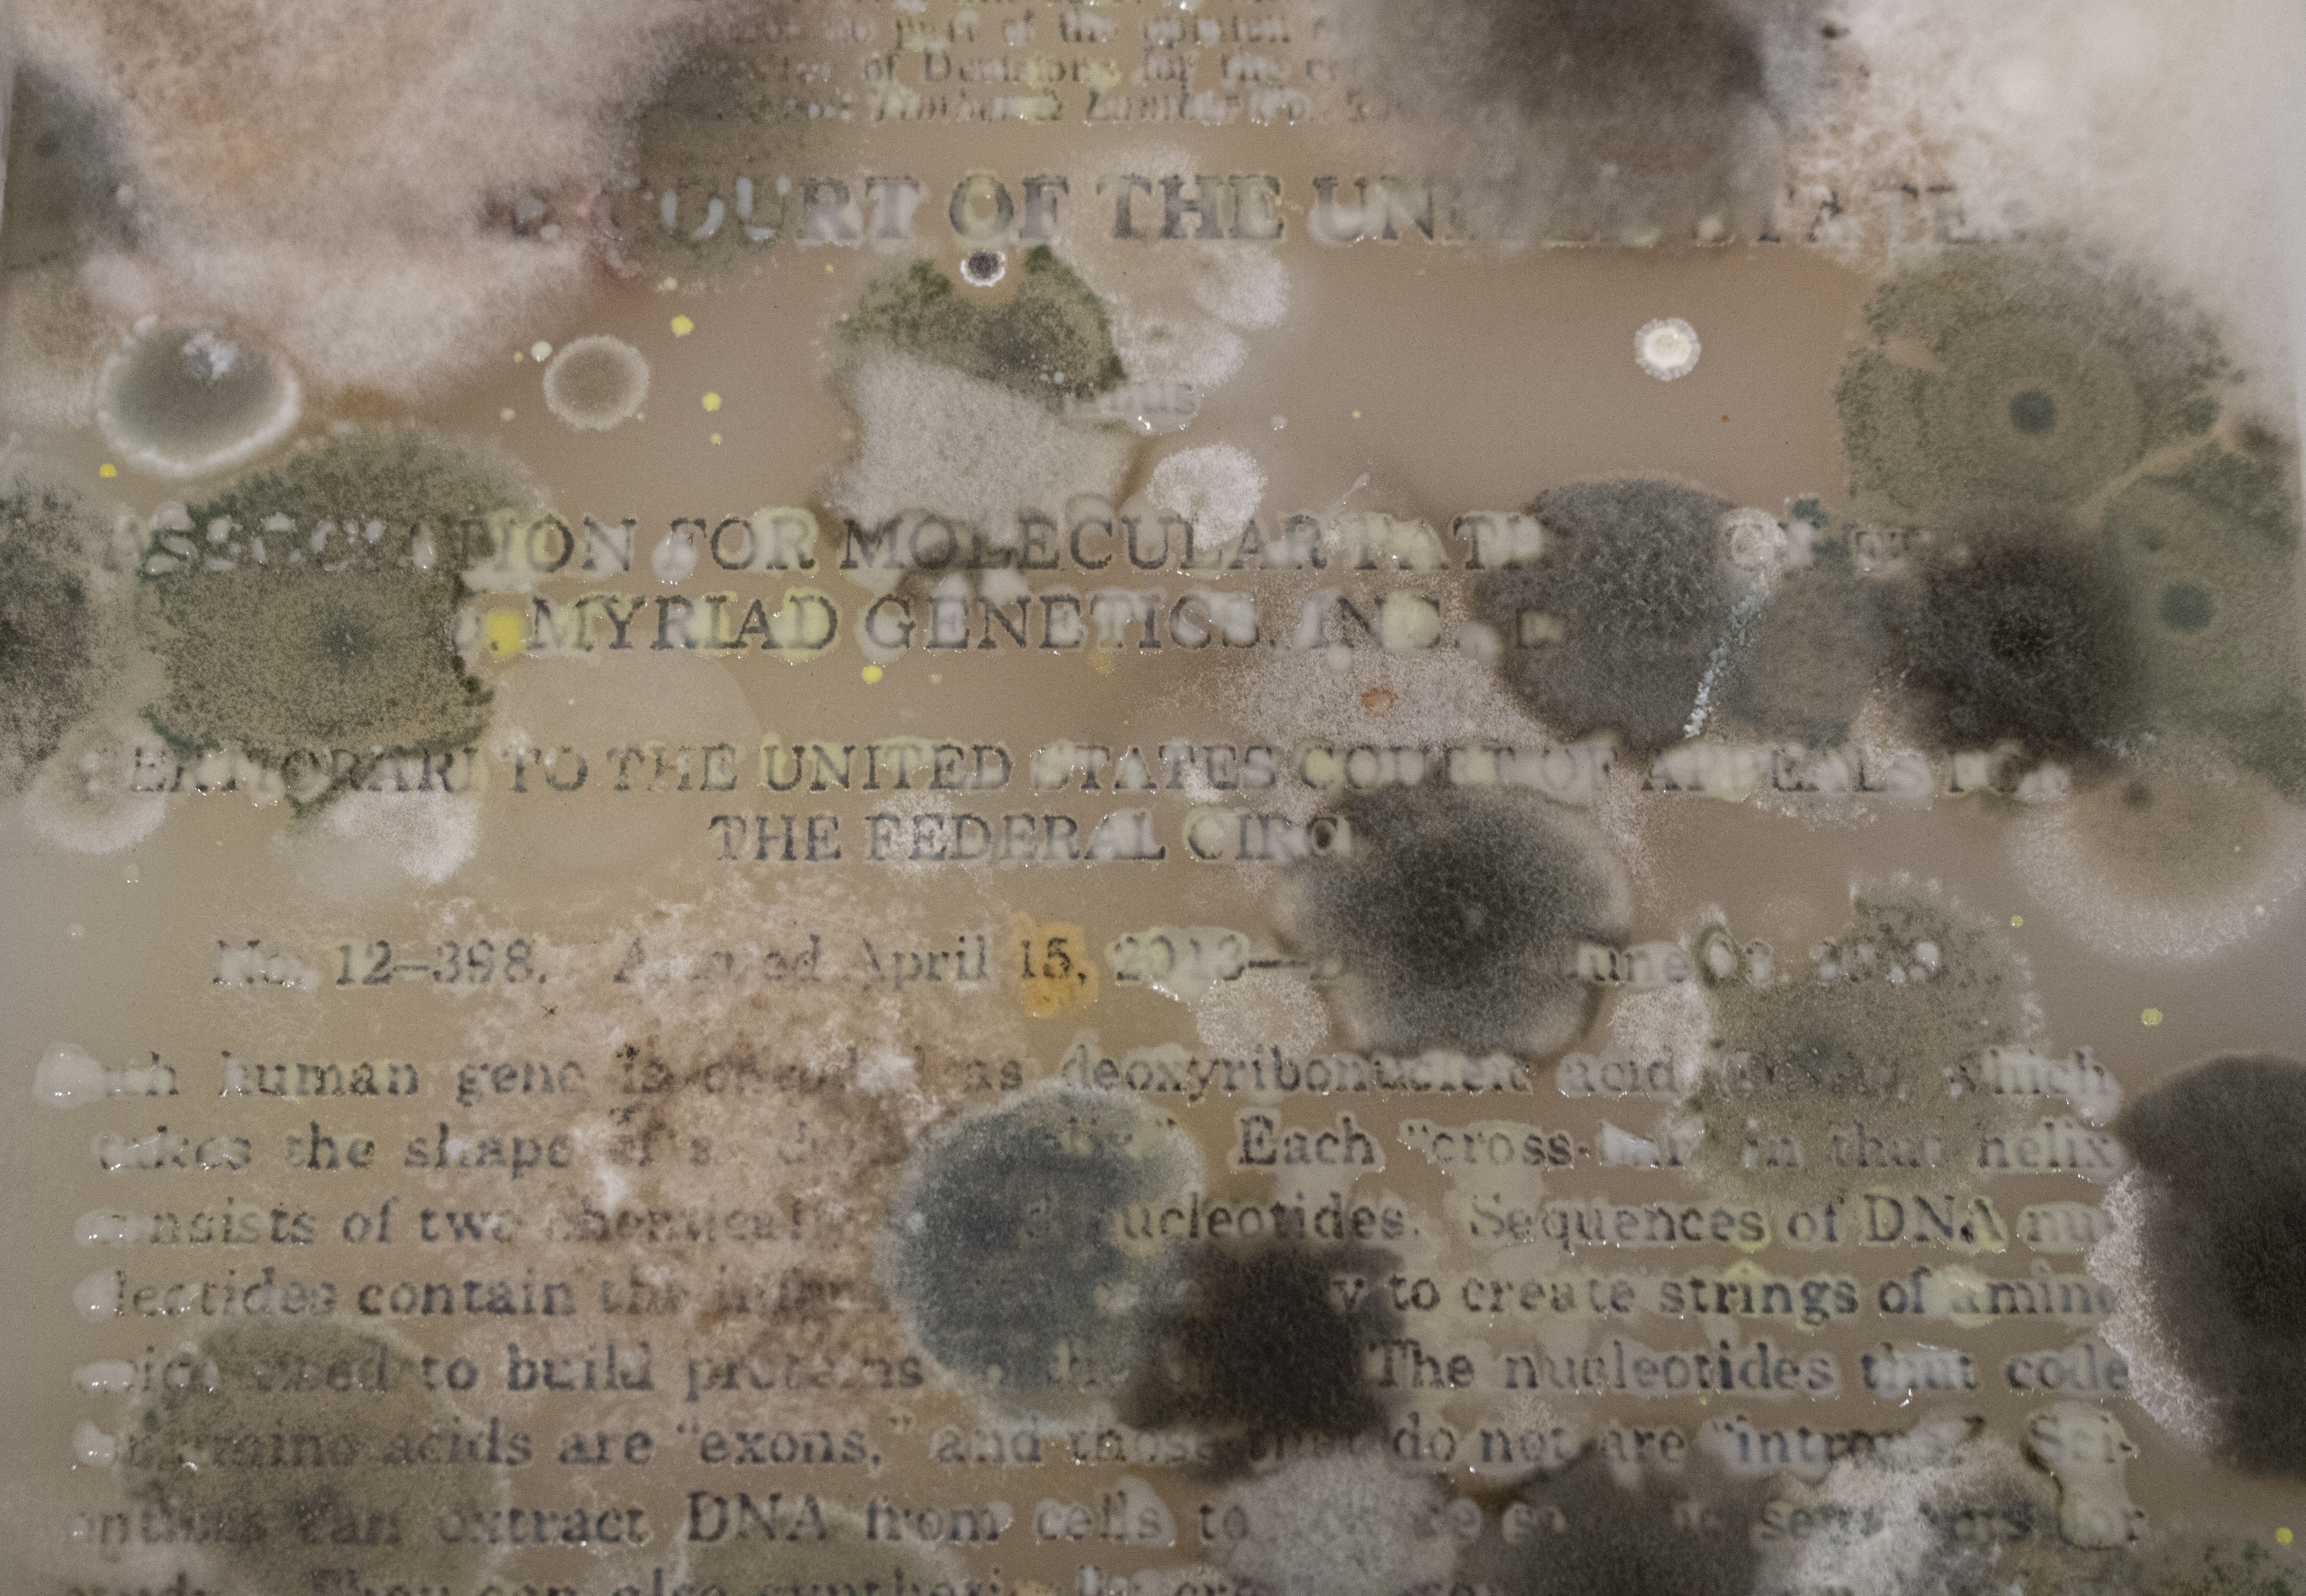

PRODUCTS OF NATURE


2019
13’’ x 19’’
Supreme Court ruling Association for Molecular Pathology v. Myriad Genetics, Inc. screen printed on bacterial culture growth medium cast in a petri dish for hosting bacterial colonies, creating a living document.
PRODUCTS OF NATURE (IN BLOOM)